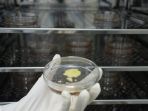

Kimia Farma dan Kalbe Jalin Sinergi, Mudahkan Pasien Nebus Obat Tanpa Harus ke Apotek
Kimia Farma dan Kalbe menandatangani nota kesepahaman saling bersinergi dan berkolaborasi di bidang layanan kesehatan ke masyarakat Indonesia.
Laporan Wartawan Tribunnews, Willy Widianto
TRIBUNNEWS.COM, JAKARTA - PT Kimia Farma Tbk (Kimia Farma) dan PT Kalbe Farma Tbk (Kalbe) menandatangani nota kesepahaman (MoU) saling bersinergi dan berkolaborasi di bidang layanan kesehatan ke masyarakat Indonesia.
MoU tentang Pengembangan Kerja Sama Strategis Bidang Layanan Kesehatan ini menjadi landasan strategis bagi kedua perusahaan termasuk afiliasi atau entitas anak usahanya untuk melakukan kerjasama melalui berbagai aktivitas, kegiatan, dan transaksi.
Pada saat yang sama, PT Medika Komunika Teknologi (KlikDokter), anak perusahaan Kalbe yang bergerak di bidang bidang layanan Kesehatan berbasis digital dan PT Kimia Farma Apotek (KFA), anak perusahaan Kimia Farma di sektor ritel kesehatan, menandatangani dua perjanjian kerjasama.
Pertama, perjanjian kerja sama tentang penebusan obat secara online dengan resep digital dan fisik (e-prescription dan non e-prescription) melalui aplikasi KlikDokter dan melalui marketplace KALStore yang dilakukan pelayanannya melalui outlet apotek KFA.
Kedua, perjanjian kerja sama tentang layanan telemedicine melalui video call pada aplikasi Kimia Farma Mobile.
Direktur Utama PT Kimia Farma Tbk, David Utama mengatakan Kimia farma merupakan perusahaan healthcare terintegrasi dari hulu ke hilir dan menjadi bagian dari Holding BUMN Farmasi di bawah PT Bio Farma (Persero).
Pihakya terus berkomitmen meningkatkan kualitas dan akses layanan kesehatan kepada seluruh masyarakat Indonesia.
“Peningkatan kualitas layanan dan akses kesehatan ini telah dilakukan Kimia Farma melalui berbagai kolaborasi dengan para mitra strategis. Kali ini kami bangga bisa berkolaborasi dengan salah satu industri farmasi terbesar di tanah air, Kalbe Farma," ujar David.
Baca juga: Kalbe dan Samudera Kembangkan Logistik Digital Mostrans
David menjelaskan, MoU pengembangan kerja sama strategis bidang layanan kesehatan ini menjadi bentuk komitmen Kimia Farma dan Kalbe dalam mendukung program kesehatan pemerintah melalui upaya preventif dan promotif.
MoU juga mencakup kolaborasi pemasaran dan penjualan masing-masing produk kedua perusahaan baik secara offline maupun online.
"Kerja sama Kalbe dan Kimia Farma merupakan bagian dari kontribusi bersama untuk meningkatkan akses kesehatan bagi masyarakat dan mewujudkan masyarakat Indonesia yang sehat. Bersama Sehatkan Bangsa,” kata Vidjongtius, Presiden Direktur PT Kalbe Farma Tbk.
Baca juga: Ekspansi Bisnis, Kimia Farma Buka 15 Outlet Baru dan Garap Pasar E-Commerce
"Kalbe juga berkomitmen untuk membantu pemerintah dalam meningkatkan kemandirian kesehatan di Indonesia,” lanjutnya.
Menurut Vidjongtius, pada tahap awal, kerja sama dengan Kimia Farma akan dilakukan oleh KlikDokter, anak perusahaan Kalbe yang bergerak pada layanan kesehatan berbasis digital kesehatan.
KlikDokter akan bekerja sama dengan KFA untuk proses penebusan obat secara online melalui aplikasi KlikDokter untuk obat resep dan nonresep serta melalui marketplace KALStore untuk produk nutrisi, suplemen, dan produk kesehatan lainnya.
| 800 Paket Ramadan Diberikan ke Anak Yatim dan Duafa di Beberapa Tempat |

|
|---|
| Angkat Suara Soal Penemuan Jenazah di Gudang Apotek, Kimia Farma Pastikan Karyawan Kooperatif |

|
|---|
| Bangun Fasilitas Produksi Radiofarmaka Dalam Negeri, Kalbe Dukung Penanganan Kanker di Indonesia |

|
|---|
| Syarat Daftar Lowongan Kerja Kimia Farma untuk Fresh Graduate, Klik rekrutmen.kimiafarma.co.id |

|
|---|
| Lowongan Kerja Kimia Farma untuk D3 Perawat atau Profesi Ners, Berikut Syarat dan Cara Daftar |

|
|---|



![[FULL] Puja-Puji Trump ke Prabowo, Pakar: Indonesia Ukir Sejarah Jadi Bagian Perdamaian Timur Tengah](https://img.youtube.com/vi/fJn8tji_3J8/mqdefault.jpg)

Isi komentar sepenuhnya adalah tanggung jawab pengguna dan diatur dalam UU ITE.